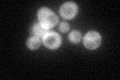
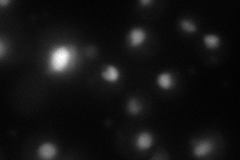
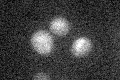

View description
Trimeric heat shock transcription factor, activates multiple genes in response to stresses that include hyperthermia; recognizes variable heat shock elements (HSEs) consisting of inverted NGAAN repeats; posttranslationally regulated
Localization:
Intensity:
Fold change:
Significance:
-
C’ GFP library in SD
cytosol53.3 -
N' NOP1pr-GFP in SD
nucleolus61.9007 -
N' TEF2pr-mCherry in SD

nucleus84.6391 -
N' NATIVEpr-GFP in SD

nucleus32.2183 -
N' TEF2pr-VC and Cyto-VN in SD

nucleus40.6429 -
C’ GFP library in SD+DTT

cytosol26.460.49Yes -
C’ GFP library in SD+H2O2

cytosol22.270.41No -
C’ GFP library in Starvation Media
cytosol17.60.33No -
C’ GFP library on the background of Pup2-DaMP

cytosol -
C’ GFP library on the background of CCT mutant

cytosol28.33510.531587Yes
